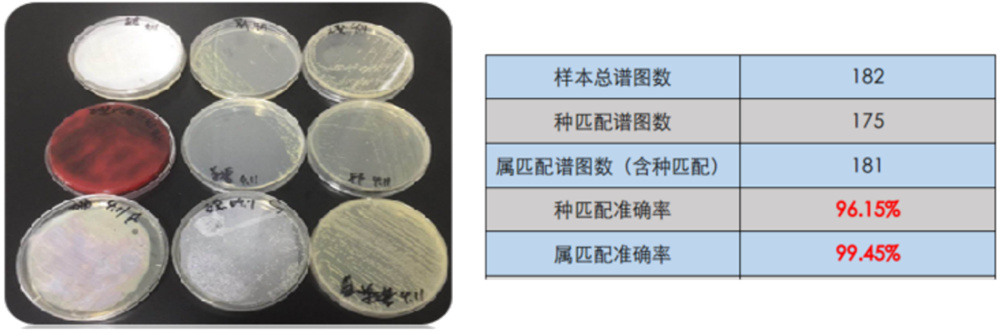
中国·tyc7111cc太阳成

例如生活饮用水和食物受到致病菌、有毒有害物质或次生化学物质的污染,食用了受污染的食物会对人体健康造成严重影响,引发腹泻、痢疾等疾病,甚至可能引发传染性疾病的流行。
为了更好地支持汛期食品安全检测工作,禾信仪器不断完善汛期食品解决方案,为保障汛期食品安全提供有力的科技支持,为广大人民群众的健康保驾护航。
01.重金属分析
应用电感耦合等离子体质谱仪ICP-MS 1600,对污水中的重金属进行分析。
电感耦合等离子体质谱仪ICP-MS 1600
参考标准:HJ 700-2014《水质 65种元素的测定 电感耦合等离子体质谱法》。
根据《环境监测分析方法标准制订技术导则》(HJ 168-2020),按照污染分析的全部步骤。结果显示,线性相关系数R2均大于0.9999,显著优于标准R2>0.999的要求,实测检出限均小于标准要求检出限。

参考标准:HJ 700-2014《水质 65种元素的测定 电感耦合等离子体质谱法》。
根据《环境监测分析方法标准制订技术导则》(HJ 168-2020),按照污染分析的全部步骤。结果显示,线性相关系数R2均大于0.9999,显著优于标准R2>0.999的要求,实测检出限均小于标准要求检出限。
根据《环境监测分析方法标准制订技术导则》(HJ 168-2020),按照污染分析的全部步骤。结果显示,线性相关系数R2均大于0.9999,显著优于标准R2>0.999的要求,实测检出限均小于标准要求检出限。

参考标准:HJ 700-2014《水质 65种元素的测定 电感耦合等离子体质谱法》。
根据《环境监测分析方法标准制订技术导则》(HJ 168-2020),按照污染分析的全部步骤。结果显示,线性相关系数R2均大于0.9999,显著优于标准R2>0.999的要求,实测检出限均小于标准要求检出限。
02.菌种鉴定
食源性疾病的爆发对公共卫生和食品行业都是巨大的危害。市场监督管理局大批量抽检,不合格项目主要来源于3类问题:微生物污染、农兽药残留指标、超范围超限量使用食品添加剂。

全自动微生物质谱检测系统CMI-3800
应用全自动微生物质谱检测系统CMI-3800,对食源性微生物检验。结果表明:仪器性能稳定,鉴定结果高度可信率达到96%,无鉴定失败样品。

应用全自动微生物质谱检测系统CMI-3800,对疾控菌种鉴定分析。
鉴定菌株:含藤黄微球菌、短小芽孢杆菌、耶尔森菌、白念菌、鲁氏不动杆菌、大肠杆菌、枯草芽孢杆菌、化脓性链球菌、金黄色葡萄球菌、表葡、志贺菌。
共14种细菌样品182株菌,鉴定准确率达95%以上。

03.水质异味分析
应用全二维气相色谱飞行时间质谱联用仪GGT 0620,对异味水质进行分析

应用全自动微生物质谱检测系统CMI-3800,对疾控菌种鉴定分析。
鉴定菌株:含藤黄微球菌、短小芽孢杆菌、耶尔森菌、白念菌、鲁氏不动杆菌、大肠杆菌、枯草芽孢杆菌、化脓性链球菌、金黄色葡萄球菌、表葡、志贺菌。
共14种细菌样品182株菌,鉴定准确率达95%以上。
03.水质异味分析
应用全二维气相色谱飞行时间质谱联用仪GGT 0620,对异味水质进行分析

全二维气相色谱飞行时间质谱联用仪GGT 0620
问题:自来水有明显的异味,无法查明原因。
检测方法:GGT 0620 进行有机成分精细分析。
分析结果:GCMS:检出不到40种成分,共流出现象明显;GGT 0620:检出约150种挥发性成分,测出药水味来源(碘仿)、刺激性气味来源(卤代烃、苯系物等),工业排放特征明显,为精准溯源提供数据支撑。

04.真菌毒素检测
应用三重四极杆液质联用仪LC-TQ 5200,对大米中的真菌毒素进行分析。
检测方法:GGT 0620 进行有机成分精细分析。
分析结果:GCMS:检出不到40种成分,共流出现象明显;GGT 0620:检出约150种挥发性成分,测出药水味来源(碘仿)、刺激性气味来源(卤代烃、苯系物等),工业排放特征明显,为精准溯源提供数据支撑。

04.真菌毒素检测
应用三重四极杆液质联用仪LC-TQ 5200,对大米中的真菌毒素进行分析。

三重四极杆液质联用仪LC-TQ 5200
参考标准:GB 5009.22-2016《食品安全国家标准 食品中黄曲霉毒素B族和G族的测定》。
采用LC-TQ 5200分析了大米样品中的4种黄曲霉毒素化合物含量。实验结果显示:本方法中4种黄曲霉毒素的方法最低定量限均为0.05 μg/kg,低于标准要求的最低定量限(0.1 μg/kg),体现了禾信仪器LC-TQ 5200具有优异的灵敏度,满足食品中黄曲霉毒素B族和G族的检测要求。

采用LC-TQ 5200分析了大米样品中的4种黄曲霉毒素化合物含量。实验结果显示:本方法中4种黄曲霉毒素的方法最低定量限均为0.05 μg/kg,低于标准要求的最低定量限(0.1 μg/kg),体现了禾信仪器LC-TQ 5200具有优异的灵敏度,满足食品中黄曲霉毒素B族和G族的检测要求。

三重四极杆液质联用仪LC-TQ 5200
禾信仪器在守护汛期食品安全方面表现出色,凭借先进的质谱技术,有效地检测和分析食品中的有害物质,确保食品的质量和安全。秉持“做中国人的质谱仪器”理念,禾信仪器以创新科技为支撑,为舌尖上的安全保驾护航。


您的位置:


